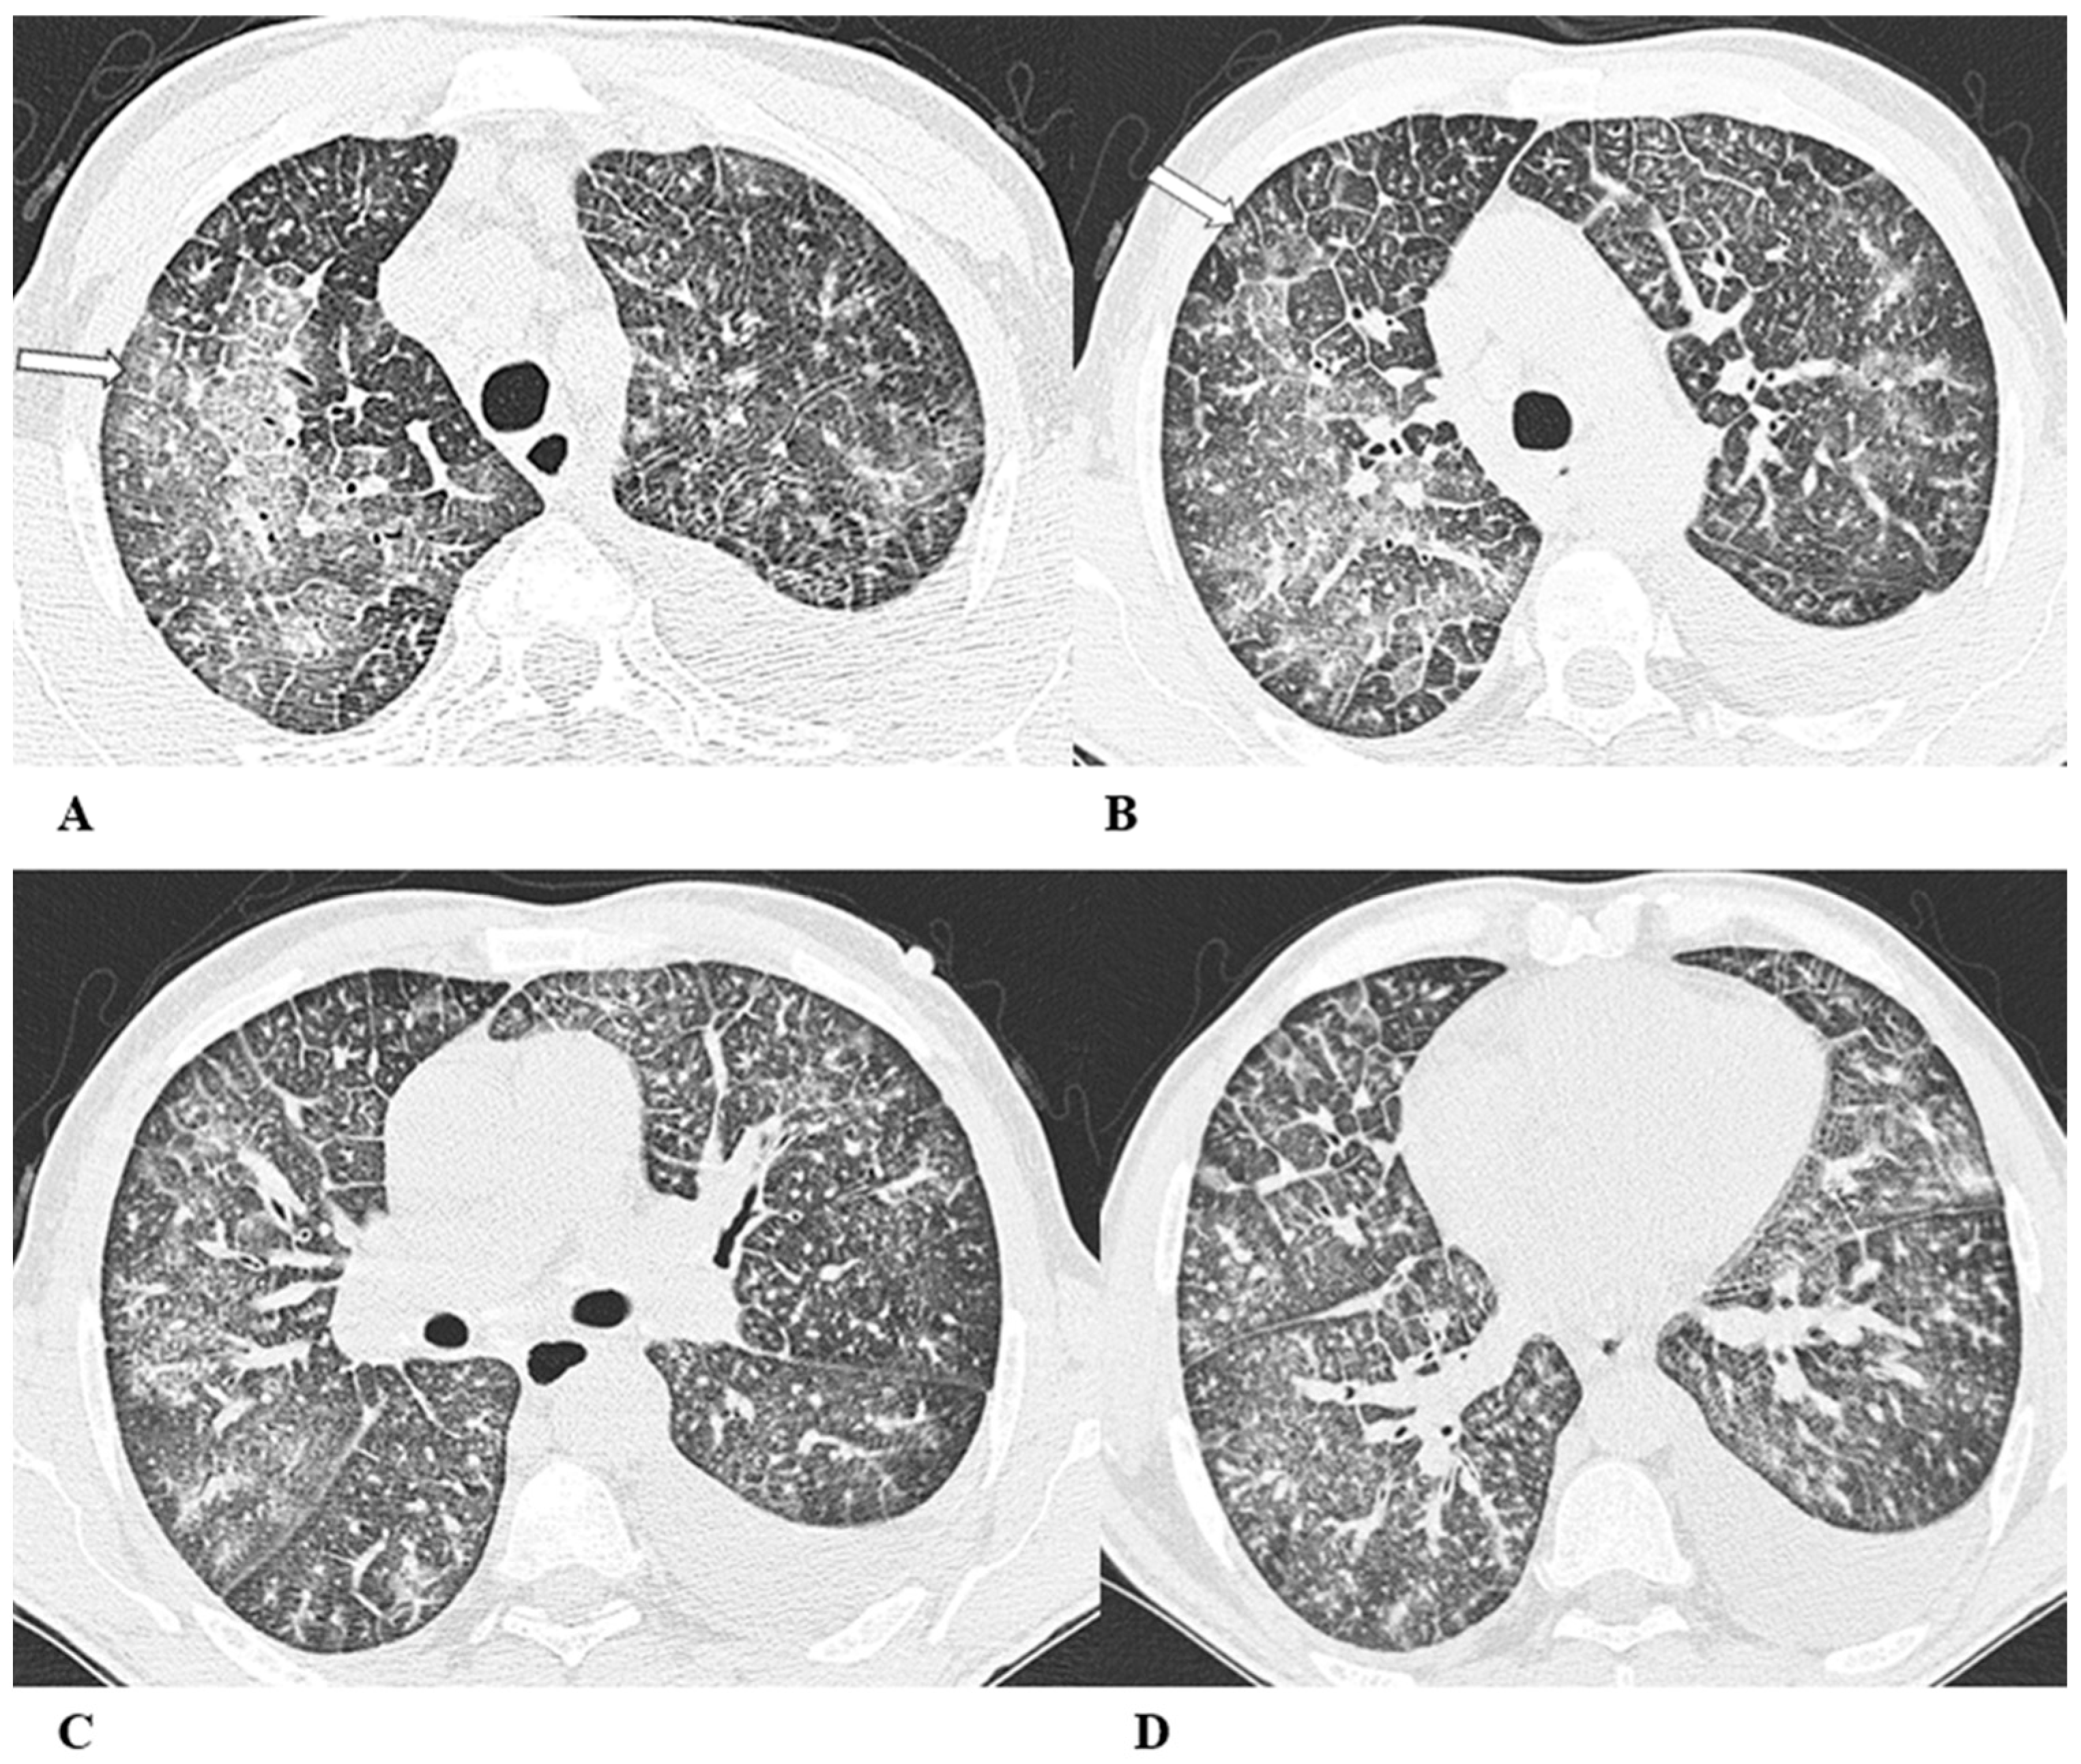
Diagnostics 14 00613 g006

Pulmonary Adverse Events in Cancer Immunotherapy: Case Studies of CT Patterns
Abstract

Author Contributions
Funding
Institutional Review Board Statement
Informed Consent Statement
Data Availability Statement
Conflicts of Interest
References
- Pardoll, D. The blockade of immune checkpoints in cancer immunotherapy. Nat. Rev. Cancer 2012, 12, 252–264. [Google Scholar] [CrossRef]
- Vaddepally, R.K.; Kharel, P.; Pandey, R.; Garje, R.; Chandra, A.B. Review of Indications of FDA-Approved Immune Checkpoint Inhibitors per NCCN Guidelines with the Level of Evidence. Cancers 2020, 12, 738. [Google Scholar] [CrossRef]
- Ramos-Casals, M.; Brahmer, J.R.; Callahan, M.K.; Flores-Chávez, A.; Keegan, N.; Khamashta, M.A.; Lambotte, O.; Mariette, X.; Prat, A.; Suárez-Almazor, M.E. Immune-related adverse events of checkpoint inhibitors. Nat. Rev. Dis. Primers 2020, 6, 38. [Google Scholar] [CrossRef]
- Cadranel, J.; Canellas, A.; Matton, L.; Darrason, M.; Parrot, A.; Naccache, J.-M.; Lavolé, A.; Ruppert, A.-M.; Fallet, V. Pulmonary complications of immune checkpoint inhibitors in patients with nonsmall cell lung cancer. Eur. Respir. Rev. 2019, 28, 190058. [Google Scholar] [CrossRef] [PubMed]
- Sakamoto, K.; Fukihara, J.; Morise, M.; Hashimoto, N. Clinical burden of immune checkpoint inhibitor-induced pneumonitis. Respir. Investig. 2020, 58, 305–319. [Google Scholar] [CrossRef]
- Galant-Swafford, J.; Troesch, A.; Tran, L.; Weaver, A.; Doherty, T.A.; Patel, S.P. Landscape of immune-related pneumonitis in cancer patients with asthma being treated with immune checkpoint blockade. Oncology 2020, 98, 123–130. [Google Scholar] [CrossRef] [PubMed]
- Haanen, J.B.A.G.; Carbonnel, F.; Robert, C.; Kerr, K.M.; Peters, S.; Larkin, J.; Jordan, K. Management of toxicities from immunotherapy: ESMO Clinical Practice Guidelines for diagnosis, treatment and follow-up. Ann. Oncol. 2018, 29 (Suppl. S4), iv264–iv266. [Google Scholar] [CrossRef] [PubMed]
- Davies, M.J. PD-1/PD-L1 Inhibitors for Non-Small Cell Lung Cancer: Incorporating Care Step Pathways for Effective Side-Effect Management. J. Adv. Pract. Oncol. 2019, 10 (Suppl. S1), 21–35. [Google Scholar]
- Nishino, M.; Ramaiya, N.H.; Awad, M.M.; Sholl, L.M.; Maattala, J.A.; Taibi, M.; Hatabu, H.; Ott, P.A.; Armand, P.F.; Hodi, F.S. PD-1 inhibitor-related pneumonitis in advanced cancer patients: Radiographic patterns and clinical course. Clin. Cancer Res. 2016, 22, 6051–6060. [Google Scholar] [CrossRef]
- Naidoo, J.; Wang, X.; Woo, K.M.; Iyriboz, T.; Halpenny, D.; Cunningham, J.; Chaft, J.E.; Segal, N.H.; Callahan, M.K.; Lesokhin, A.M.; et al. Pneumonitis in Patients Treated with Anti-Programmed Death-1/Programmed Death Ligand 1 Therapy. J. Clin. Oncol. 2017, 35, 709–717. [Google Scholar] [CrossRef]
- Nishino, M.; Sholl, L.M.; Awad, M.M.; Hatabu, H.; Armand, P.; Hodi, F.S. Sarcoid-like granulomatosis of the lung related to immune-checkpoint inhibitors: Distinct clinical and imaging features of a unique immune-related adverse event. Cancer Immunol. Res. 2018, 6, 630–635. [Google Scholar] [CrossRef]
- Johkoh, T.; Lee, K.S.; Nishino, M.; Travis, W.D.; Ryu, J.H.; Lee, H.Y.; Ryerson, C.J.; Franquet, T.; Bankier, A.A.; Brown, K.K.; et al. Chest CT Diagnosis and Clinical Management of Drug-related Pneumonitis in Patients Receiving Molecular Targeting Agents and Immune Checkpoint Inhibitors: A Position Paper from the Fleischner Society. Radiology 2021, 298, 550–566. [Google Scholar] [CrossRef]
- Tetzlaff, M.T.; Nelson, K.C.; Diab, A.; Staerkel, G.A.; Nagarajan, P.; Torres-Cabala, C.A.; Chasen, B.A.; Wargo, J.A.; Prieto, V.G.; Amaria, R.N.; et al. Granulomatous/sarcoid-like lesions associated with checkpoint inhibitors: A marker of therapy response in a subset of melanoma patients. J. Immunother. Cancer 2018, 6, 14. [Google Scholar] [CrossRef]
- Jodai, T.; Yoshida, C.; Sato, R.; Kakiuchi, Y.; Sato, N.; Iyama, S.; Kimura, T.; Saruwatari, K.; Saeki, S.; Ichiyasu, H.; et al. A potential mechanism of the onset of acute eosinophilic pneumonia triggered by an anti-PD-1 immune checkpoint antibody in a lung cancer patient. Immun. Inflamm. Dis. 2019, 7, 3–6. [Google Scholar] [CrossRef] [PubMed]
- Hara, K.; Yamasaki, K.; Tahara, M.; Kimuro, R.; Yamaguchi, Y.; Suzuki, Y.; Kawabata, H.; Kawanami, T.; Fujimoto, N.; Yatera, K. Immune checkpoint inhibitors-induced eosinophilic pneumonia: A case report. Thorac. Cancer 2021, 12, 720–724. [Google Scholar] [CrossRef]
- Kligerman, S.J.; Franks, T.J.; Galvin, J.R. From the radiologic pathology archives: Organization and fibrosis as a response to lung injury in diffuse alveolar damage, organizing pneumonia, and acute fibrinous and organizing pneumonia. Radiographics 2013, 33, 1951–1975. [Google Scholar] [CrossRef] [PubMed]
- Rea, G.; Bocchino, M.; Lieto, R.; Ledda, R.E.; D’Alto, M.; Sperandeo, M.; Lucci, R.; Pasquinelli, P.; Sanduzzi Zamparelli, S.; Bocchini, G.; et al. The Unveiled Triad: Clinical, Radiological and Pathological Insights into Hypersensitivity Pneumonitis. J. Clin. Med. 2024, 13, 797. [Google Scholar] [CrossRef] [PubMed]
- Takeda, K.; Miwa, H.; Kono, M.; Hirama, R.; Oshima, Y.; Mochizuka, Y.; Tsutsumi, A.; Miki, Y.; Hashimoto, D.; Nakamura, H. Bronchiolitis obliterans syndrome associated with an immune checkpoint inhibitor in a patient with non-small cell lung cancer. Respir. Med. Case Rep. 2023, 26, 101824. [Google Scholar] [CrossRef] [PubMed]
- Balagani, A.; Arain, M.H.; Sheshadri, A. Bronchiolitis obliterans after combination immunotherapy with pembrolizumab and ipilimumab. J. Immunother. Precision Oncol. 2020, 1, 49–52. [Google Scholar] [CrossRef]
- Price, M.; Gilman, M.D.; Carter, B.W.; Sabloff, B.S.; Truong, M.T.; Wu, C.C. Imaging of Eosinophilic Lung Diseases. Radiol. Clin. N. Am. 2016, 54, 1151–1164. [Google Scholar] [CrossRef]
- Chorti, E.; Kanaki, T.; Zimmer, L.; Hadaschik, E.; Ugurel, S.; Gratsias, E.; Roesch, A.; Bonella, F.; Wessendorf, T.E.; Wälscher, J.; et al. Drug-induced sarcoidosis-like reaction in adjuvant immunotherapy: Increased rate and mimicker of metastasis. Eur. J. Cancer 2020, 131, 18–26. [Google Scholar] [CrossRef]
- Mallio, C.A.; Bernetti, C.; Cea, L.; Buoso, A.; Stiffi, M.; Vertulli, D.; Greco, F.; Zobel, B.B. Adverse Effects of Immune-Checkpoint Inhibitors: A Comprehensive Imaging-Oriented. Review. Curr. Oncol. 2023, 30, 4700–4723. [Google Scholar] [CrossRef]
- Ciccarese, F.; Piccinino, A.; Brocchi, S.; Balacchi, C.; Dall’olio, F.G.; Massari, F.; Rihawi, K.; Paccapelo, A.; Ardizzoni, A.; Golfieri, R. Expected and non-expected immune-related adverse events detectable by CT. Eur. J. Radiol. 2021, 138, 109617. [Google Scholar] [CrossRef] [PubMed]
- McGovern, K.; Ghaly, M.; Esposito, M.; Barnaby, K.; Seetharamu, N. Radiation recall pneumonitis in the setting of immunotherapy and radiation: A focused review. Future Sci. 2019, 5, FSO378. [Google Scholar] [CrossRef] [PubMed]
- Nishino, M.; Hatabu, H.; Hodi, F.S. Imaging of Cancer immunotherapy: Current approaches and future directions. Radiology 2019, 290, 9–22. [Google Scholar] [CrossRef] [PubMed]
- Robert, C. A decade of immune-checkpoint inhibitors in cancer therapy. Nat. Commun. 2020, 11, 3801. [Google Scholar] [CrossRef] [PubMed]
- Das, S.; Johnson, D.B. Immune-related adverse events and anti-tumor efficacy of immune checkpoint inhibitors. J. Immunother. Cancer 2019, 7, 306. [Google Scholar] [CrossRef]
- Toi, Y.; Sugawara, S.; Kawashima, Y.; Aiba, T.; Kawana, S.; Saito, R.; Tsurumi, K.; Suzuki, K.; Shimizu, H.; Sugisaka, J.; et al. Association of Immune-Related Adverse Events with Clinical Benefit in Patients with Advanced Non-Small-Cell Lung Cancer Treated with Nivolumab. Oncologist 2018, 23, 1358–1365. [Google Scholar] [CrossRef] [PubMed]
- Hua, C.; Boussemart, L.; Mateus, C.; Routier, E.; Boutros, C.; Cazenave, H.; Viollet, R.; Thomas, M.; Roy, S.; Benannoune, N.; et al. Association of Vitiligo with Tumor Response in Patients with Metastatic Melanoma Treated with Pembrolizumab. JAMA Dermatol. 2016, 152, 45–51. [Google Scholar] [CrossRef]
- U.S. Department of Health and Human Services; NIH; NCI. Common Terminology Criteria for Adverse Events (CTCAE). 2017. Available online: https://ctep.cancer.gov (accessed on 27 November 2017).
- Terbuch, A.; Tiu, C.; Candilejo, I.M.; Scaranti, M.; Curcean, A.; Bar, D.; Estevez Timon, M.; Ameratunga, M.; Ang, J.E.; Ratoff, J.; et al. Radiological Patterns of Drug-induced Interstitial Lung Disease (DILD) in Early-phase Oncology Clinical Trials. Clin. Cancer Res. 2020, 26, 4805–4813. [Google Scholar] [CrossRef]
- Lynch, D.A.; Godwin, J.D.; Safrin, S.; Starko, K.M.; Hormel, P.; Brown, K.K.; Raghu, G.; King, T.E., Jr.; Bradford, W.Z.; Schwartz, D.A.; et al. High-resolution computed tomography in idiopathic pulmonary fibrosis: Diagnosis and prognosis. Am. J. Respir. Crit. Care Med. 2005, 172, 488–493. [Google Scholar] [CrossRef] [PubMed]
- Yang, R.; Li, X.; Liu, H.; Zhen, Y.; Zhang, X.; Xiong, Q.; Luo, Y.; Gao, C.; Zeng, W. Chest CT Severity Score: An Imaging Tool for Assessing Severe COVID-19. Radiol. Cardiothorac. Imaging 2020, 2, e200047. [Google Scholar] [CrossRef] [PubMed]
- Suresh, K.; Naidoo, J.; Lin, C.T.; Danoff, S. Immune Checkpoint Immunotherapy for Non-Small Cell Lung Cancer: Benefits and Pulmonary Toxicities. Chest 2018, 154, 1416–1423. [Google Scholar] [CrossRef] [PubMed]
- Kalisz, K.R.; Ramaiya, N.H.; Laukamp, K.R.; Gupta, A. Immune Checkpoint Inhibitor Therapy–related Pneumonitis: Patterns and Management. RadioGraphics 2019, 39, 1923–1937. [Google Scholar] [CrossRef] [PubMed]
- Watanabe, S.; Kimura, H.; Takato, H.; Waseda, Y.; Hara, J.; Sone, T.; Abo, M.; Maeda, S.; Matsushita, T.; Kasahara, K. Severe pneumonitis after nivolumab treatment in a patient with melanoma. Allergol. Int. 2016, 65, 487–489. [Google Scholar] [CrossRef]
- Garg, M.; Prabhakar, N.; Gulati, A.; Agarwal, R.; Dhooria, S. Spectrum of imaging findings in pulmonary infections. Part 1: Bacterial and viral. Pol. J. Radiol. 2019, 84, e205–e213. [Google Scholar] [CrossRef]
- Diederich, S. Chest CT for suspected pulmonary complications of oncologic therapies: How I review and report. Cancer Imaging 2016, 16, 7. [Google Scholar] [CrossRef] [PubMed]
- Tohidinezhad, F.; Bontempi, D.; Zhang, Z.; Dingemans, A.-M.; Aerts, J.; Bootsma, G.; Vansteenkiste, J.; Hashemi, S.; Smit, E.; Gietema, H.; et al. Computed tomography-based radiomics for the differential diagnosis of pneumonitis in stage IV non-small cell lung cancer patients treated with immune checkpoint inhibitors. Eur. J. Cancer 2023, 183, 142–151. [Google Scholar] [CrossRef]
- Rea, G.; Sverzellati, N.; Bocchino, M.; Lieto, R.; Milanese, G.; D’Alto, M.; Bocchini, G.; Maniscalco, M.; Valente, T.; Sica, G. Beyond Visual Interpretation: Quantitative Analysis and Artificial Intelligence in Interstitial Lung Disease Diagnosis “Expanding Horizons in Radiology”. Diagnostics 2023, 13, 2333. [Google Scholar] [CrossRef]
- Cheng, J.; Pan, Y.; Huang, W.; Huang, K.; Cui, Y.; Hong, W.; Wang, L.; Ni, D.; Tan, P. Differentiation between immune checkpoint inhibitor-related and radiation pneumonitis in lung cancer by CT radiomics and machine learning. Med. Phys. 2022, 49, 1547–1558. [Google Scholar] [CrossRef]

| Immune-Checkpoint Inhibitor | Targets | US FDA/EMA-Approved Indications | China NMPA-Approved Indications |
|---|---|---|---|
| Pembrolizumab | PD-1 | Melanoma, non-small-cell lung cancer, head and neck cancer, Hodgkin’s lymphoma, urothelial carcinoma, MSI-H/dMMR colorectal cancer, gastric cancer, cervical cancer, hepatocellular carcinoma, Merkel cell carcinoma, renal cell carcinoma, small-cell lung cancer, esophageal carcinoma, endometrial cancer, myelodysplasiadata | Melanoma, non-small-cell lung cancer, head and neck cancer, MSI-H/dMMR colorectal cancer, esophageal squamous cancer, hepatocellular carcinoma |
| Nivolumab | PD-1 | Melanoma, non-small-cell lung cancer, renal cell carcinoma, Hodgkin’s lymphoma, head and neck cancer, urothelial carcinoma, MSI-H/dMMR colorectal cancer, hepatocellular carcinoma, small-cell lung cancer | Non-small-cell lung cancer, head and neck cancer, esophageal squamous cancer, gastric cancer |
| Cemiplimab | PD-1 | Cutaneous squamous cell carcinoma | |
| Toripalimab | PD-1 | Nasopharyngeal carcinoma | Melanoma, nasopharyngeal carcinoma |
| Sintilimab | PD-1 | Hodgkin’s lymphoma, non-small-cell lung cancer, esophageal cancer, hepatocellular carcinoma, gastric cancer | |
| Camrelizumab | PD-1 | Hodgkin’s lymphoma, esophageal squamous carcinoma, Non-small-cell lung cancer, hepatocellular carcinoma, nasopharyngeal carcinoma | |
| Tislelizumab | PD-1 | Non-small-cell lung cancer, esophageal squamous carcinoma | Hodgkin’s lymphoma, non-small-cell lung cancer, esophageal squamous carcinoma, nasopharyngeal carcinoma hepatocellular carcinoma, uroepithelial carcinoma |
| Penpulimab | PD-1 | Hodgkin’s lymphoma, non-small-cell lung cancer, nasopharyngeal carcinoma | |
| Zimberelimab | PD-1 | Hodgkin’s lymphoma, cervical cancer | |
| Serplulimab | PD-1 | Gastric cancer, non-small-cell lung cancer, MSI-H/dMMR colorectal cancer | |
| Pucotenlimab | PD-1 | MSI-H/dMMR colorectal cancer, melanoma | |
| Atezolizumab | PD-L1 | Urothelial cancer, non-small-cell lung cancer, breast cancer, small-cell lung cancer | Non-small-cell lung cancer |
| Durvalumab | PD-L1 | Urothelial carcinoma, non-small-cell lung cancer | |
| Avelumab | PD-L1 | Merkel cell carcinoma, urothelial carcinoma, renal cell carcinoma | |
| Envafolimab | PD-L1 | MSI-H/dMMR colorectal cancer | |
| Sugemalimab | PD-L1 | Non-small-cell lung cancer, esophageal squamous carcinoma | |
| Tremelimumab | CTLA-4 | Melanoma, non-small-cell lung cancer, renal cell carcinoma, hepatocellular carcinoma | |
| Ipilimumab | CTLA-4 | Melanoma, metastatic renal cell carcinoma, MSI-H/dMMR colorectal cancer | |
| Cadonilimab | PD-1/CTLA-4 | Cervical cancer |
| PNEUMONITIS | |
|---|---|
| Organizing pneumonia (OP) | Multifocal areas of consolidation and ground-glass opacities (GGOs) with peribronchovascular and subpleural distribution; occasionally, reversed halo signs and perilobular patterns are visible. |
| Non-specific interstitial pneumonia (NSIP) | Bilateral patchy areas of GGO, irregular reticular opacities and traction bronchiectasis with predominant lower-lung involvement. |
| Hypersensitivity pneumonitis (HP) | Bilateral lobular areas of air trapping, patchy GGO areas and poorly defined centrilobular nodules; typical basal sparing. |
| Acute interstitial pneumonia/acute respiratory distress syndrome (AIP- ARDS) | Extensive and confluent bilateral areas of GGO and/or consolidation, especially in the dependent lung. |
| Obliterative bronchiolitis (OB) | Bronchial wall thickening, occasionally bronchiectasis and centrilobular nodules are present. Areas of mosaic attenuation can be present. |
| Eosinophilic pneumonia (EP) | Bilateral and symmetrical hilar and mediastinal lymphadenopathies, sometimes associated with peribronchovascular micronodules and peribronchial interstitial thickening. |
| SARCOID-LIKE REACTIONSarcoid-like reaction (SLR) | Bilateral and symmetrical hilar and mediastinal lymphadenopathies, sometimes associated with peribronchovascular micronodules and peribronchial interstitial thickening. |
Disclaimer/Publisher’s Note: The statements, opinions and data contained in all publications are solely those of the individual author(s) and contributor(s) and not of MDPI and/or the editor(s). MDPI and/or the editor(s) disclaim responsibility for any injury to people or property resulting from any ideas, methods, instructions or products referred to in the content. |
© 2024 by the authors. Licensee MDPI, Basel, Switzerland. This article is an open access article distributed under the terms and conditions of the Creative Commons Attribution (CC BY) license (https://creativecommons.org/licenses/by/4.0/).
Share and Cite
Bocchini, G.; Imperato, M.C.; Valente, T.; Guarino, S.; Lieto, R.; Massimo, C.; Muto, E.; Romano, F.; Scaglione, M.; Sica, G.; et al. Pulmonary Adverse Events in Cancer Immunotherapy: Case Studies of CT Patterns. Diagnostics 2024, 14, 613. https://doi.org/10.3390/diagnostics14060613
Bocchini G, Imperato MC, Valente T, Guarino S, Lieto R, Massimo C, Muto E, Romano F, Scaglione M, Sica G, et al. Pulmonary Adverse Events in Cancer Immunotherapy: Case Studies of CT Patterns. Diagnostics. 2024; 14(6):613. https://doi.org/10.3390/diagnostics14060613
Chicago/Turabian StyleBocchini, Giorgio, Maria Chiara Imperato, Tullio Valente, Salvatore Guarino, Roberta Lieto, Candida Massimo, Emanuele Muto, Federica Romano, Mariano Scaglione, Giacomo Sica, and et al. 2024. "Pulmonary Adverse Events in Cancer Immunotherapy: Case Studies of CT Patterns" Diagnostics 14, no. 6: 613. https://doi.org/10.3390/diagnostics14060613
APA StyleBocchini, G., Imperato, M. C., Valente, T., Guarino, S., Lieto, R., Massimo, C., Muto, E., Romano, F., Scaglione, M., Sica, G., Vitagliano Torre, D., Masala, S., Bocchino, M., & Rea, G. (2024). Pulmonary Adverse Events in Cancer Immunotherapy: Case Studies of CT Patterns. Diagnostics, 14(6), 613. https://doi.org/10.3390/diagnostics14060613

